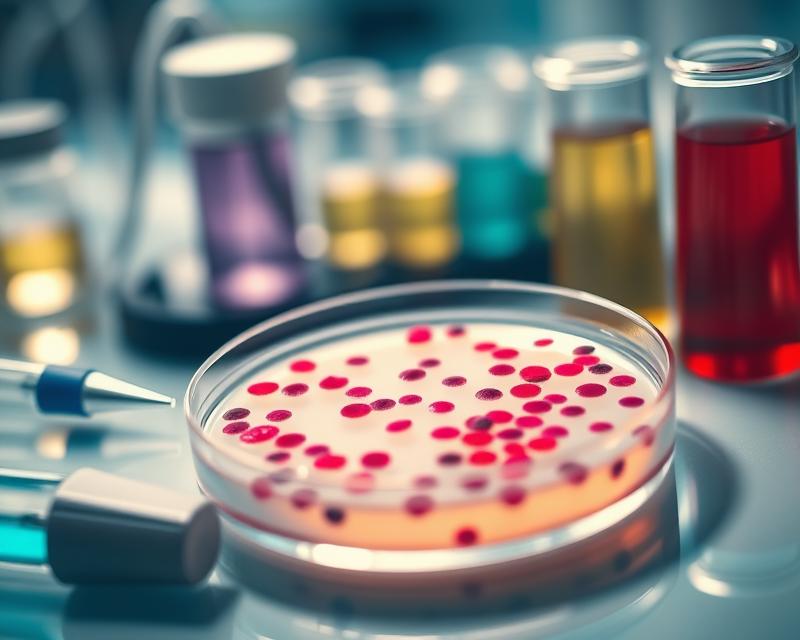

Posiew moczu to kluczowe badanie diagnostyczne, które odgrywa istotną rolę w identyfikacji bakterii odpowiedzialnych za zakażenia układu moczowego. W obliczu narastającej liczby infekcji dróg moczowych, zrozumienie tego badania oraz jego znaczenia staje się coraz bardziej aktualne. Zastosowanie odpowiednich metod pobierania próbki, jak również prawidłowa interpretacja wyników, mogą znacząco wpłynąć na skuteczność leczenia. Warto zwrócić uwagę na najczęściej wykrywane patogeny oraz na to, jakie objawy mogą sugerować konieczność wykonania posiewu moczu. W świecie, gdzie zdrowie układu moczowego jest kluczowe dla ogólnego samopoczucia, posiew moczu staje się nie tylko rutynowym badaniem, ale i narzędziem, które może uratować życie.
Co to jest posiew moczu?
Posiew moczu to istotne badanie, które pozwala na wykrywanie bakterii oraz ocenę stanu zdrowia układu moczowego. Proces ten polega na hodowli mikroorganizmów z próbki moczu, co umożliwia nam zidentyfikowanie nie tylko bakterii, ale i grzybów, a w niektórych przypadkach również wirusów. Mocz jest tworzony w nerkach poprzez filtrację krwi, dostarczając przy tym cennych informacji dotyczących potencjalnych infekcji.
Badanie to odgrywa kluczową rolę w diagnozowaniu zakażeń układu moczowego (ZUM) oraz w sytuacjach, gdy infekcje nawracają. Dzięki posiewowi, lekarze mają możliwość określenia rodzaju patogenów i dopasowania skutecznej terapii, w tym zastosowania celowanych antybiotyków. Ważnym aspektem posiewu moczu jest antybiogram, który wskazuje, na jakie leki reagują wykryte mikroorganizmy. To z kolei ma istotne znaczenie w kontekście leczenia oraz przeciwdziałania antybiotykooporności.
Aby rezultaty były wiarygodne, kluczowe jest odpowiednie pobranie próbki moczu. Przygotowania przed badaniem mają ogromne znaczenie i często przyczyniają się do poprawy jakości wyników. Posiew moczu jest szczególnie zalecany dla osób z grup ryzyka, takich jak:
- kobiety w ciąży,
- seniorzy,
- pacjenci cierpiący na cukrzycę.
Dodatkowo, warto przeprowadzić to badanie w przypadku wystąpienia objawów zakażenia, takich jak ból przy oddawaniu moczu.
Jakie są metody pobierania i przygotowania próbki moczu do badania?
Aby skutecznie przeprowadzić badanie moczu, kluczowe jest prawidłowe pobranie próbki, co zapewnia wiarygodne wyniki. Najpopularniejszą metodą jest wykorzystanie środkowego strumienia moczu. Proces ten polega na:
- oddaniu pierwszej porcji moczu do toalety,
- pobraniu moczu ze środkowej części strumienia do sterylnego pojemnika,
- ponownym oddaniu ostatniej części moczu do toalety.
Ta metoda znacząco zmniejsza ryzyko zanieczyszczenia próbki bakteriami pochodzącymi z cewki moczowej oraz skóry.
Przed przystąpieniem do pobrania próbki istotne jest:
- dokładne umycie rąk,
- zachowanie odpowiedniej higieny intymnej.
Warto użyć wody z delikatnym mydłem lub specjalnym płynem do higieny intymnej. Po myciu dobrze jest osuszyć się papierowym ręcznikiem, unikając środków antybakteryjnych, które mogą wpłynąć na wyniki analizy. Pojemnik na mocz powinien być nowy, fabrycznie zamknięty i jałowy, a jego wnętrze należy trzymać z daleka od dotyku.
Aby uzyskać jak najbardziej precyzyjne wyniki, najlepszym momentem na pobranie moczu jest poranek, po nocnym odpoczynku. Próbkę warto dostarczyć do laboratorium jak najszybciej, by ograniczyć namnażanie się bakterii w próbce. W pewnych sytuacjach, takich jak pobieranie moczu od niemowląt czy pacjentów z cewnikiem, może zachodzić potrzeba:
- zastosowania cewnikowania pęcherza moczowego,
- nakłucia nadłonowego.
Te metody pomagają zapewnić wyższą sterylność próbki.
Wybór odpowiedniej metody pobrania próbki zależy od konkretnej sytuacji klinicznej, stanu pacjenta oraz celu badania. W takich przypadkach zaleca się konsultację z lekarzem, aby wybrać najlepszą opcję.
Jak przebiega diagnostyka mikrobiologiczna posiewu moczu?
Diagnostyka mikrobiologiczna posiewu moczu polega na hodowli próbki moczu w laboratoriach, co pozwala na identyfikację drobnoustrojów wywołujących infekcje układu moczowego. Cały proces rozpoczyna się od pobrania sterylnej próbki, która jest następnie nanoszona na specjalnie przygotowane pożywki. Te pożywki stwarzają idealne warunki do wzrostu bakterii i grzybów obecnych w moczu.
Podczas inkubacji, która trwa zazwyczaj od 24 do 72 godzin w temperaturze 37°C, monitorowane są próbki. Specjaliści śledzą rozwój kolonii drobnoustrojów. Kiedy zauważą obecność bakterii lub grzybów, przystępują do ich identyfikacji oraz przeprowadzają testy na wrażliwość na antybiotyki, zwane antybiogramem. Te analizy wskazują, które leki będą najskuteczniejsze w leczeniu. W przypadku braku wzrostu mikroorganizmów, wynik badania określa się jako „posiew jałowy” lub „wynik ujemny”, co sugeruje, że infekcji nie ma.
Wyniki tej diagnostyki mają kluczowe znaczenie dla dalszych decyzji terapeutycznych oraz monitorowania stanu pacjenta. Ważne jest, aby przy interpretacji wyników uwzględnić zarówno objawy kliniczne, jak i historię choroby pacjenta, ponieważ mogą one wpływać na ostateczne zalecenia dotyczące leczenia.
Jakie patogeny najczęściej wykrywa się w posiewie moczu?
W analizach posiewu moczu najczęściej spotyka się bakterie Escherichia coli, które odpowiadają za około 90% przypadków zakażeń dróg moczowych. Ta dominacja wynika z ich powszechnego występowania w jelitach. Gdy warunki są sprzyjające, E. coli może przemieszczać się do dróg moczowych, wywołując infekcje.
Innymi ważnymi patogenami, które można wykryć w posiewie moczu, są bakterie rodzaju Klebsiella oraz Staphylococcus, w tym Staphylococcus saprophyticus. Choć występują rzadziej niż E. coli, mogą stanowić zagrożenie, szczególnie dla osób z osłabionym systemem immunologicznym lub cewnikowanych.
Diagnostyka mikrobiologiczna posiewu moczu jest niezwykle istotna. Umożliwia nie tylko potwierdzenie obecności zakażenia, ale także precyzyjne określenie rodzaju bakterii, co jest kluczowe dla skutecznego leczenia.
Dokładna identyfikacja patogenów sprzyja właściwemu doborowi antybiotyków, co zyskuje na znaczeniu w kontekście rosnącej oporności na te leki. Ponadto, uwzględnienie wyników posiewu jest niezbędne, by uniknąć niewłaściwego leczenia, które mogłoby prowadzić do dalszych komplikacji.
Jakie czynniki mogą zanieczyścić próbkę moczu?
Zanieczyszczenie próbki moczu ma istotny wpływ na wyniki badań, dlatego warto dołożyć wszelkich starań, aby go uniknąć. Istnieje kilka kluczowych czynników, które mogą przyczynić się do tego problemu.
- niewłaściwe pobranie próbki,
- niejałowy pojemnik,
- metoda pobierania.
Po pierwsze, niewłaściwe pobranie próbki to jeden z głównych powodów, dla których wyniki mogą być zaburzone. Korzystanie z niejałowego pojemnika znacząco zwiększa ryzyko wprowadzenia niepożądanych bakterii. Ważne jest, aby pojemnik był zawsze sterylny, co pomaga zredukować to ryzyko. Dodatkowo, pobieranie całego strumienia moczu, zamiast jedynie jego środkowej części, również może prowadzić do zanieczyszczenia. Dlatego zaleca się stosowanie techniki tzw. środkowego strumienia moczu. Umożliwia to ograniczenie liczby bakterii, które mogą pochodzić z cewki moczowej. W moim doświadczeniu przestrzeganie tej techniki zdecydowanie poprawia jakość próbki.
Innym istotnym czynnikiem jest cewnikowanie. Choć jest to popularna metoda diagnostyczna, może wprowadzać dodatkowe bakterie, jeżeli nie zostanie przeprowadzona w sposób aseptyczny. Warto pamiętać, że każdy etap pobierania próbki ma ogromne znaczenie dla końcowych wyników.
Dokładne przygotowanie oraz odpowiednie techniki pobierania próbki moczu są kluczowe dla uzyskania wiarygodnych wyników badań mikrobiologicznych.
Dlatego zawsze należy stosować się do obowiązujących wytycznych dotyczących tego procesu.
Jak odczytywać wyniki posiewu moczu i jakie jest znaczenie antybiogramu?
Wyniki posiewu moczu klasyfikowane są do dwóch głównych kategorii: dodatnich i ujemnych.
Dodatni wynik wskazuje na obecność patogenów w moczu, co sugeruje, że doszło do zakażenia układu moczowego. Z kolei wynik ujemny oznacza brak wykrycia drobnoustrojów, co może sugerować, że infekcji nie ma.
Antybiogram odgrywa kluczową rolę w diagnostyce, ponieważ pokazuje, jak wrażliwe są wyizolowane patogeny na różne antybiotyki. Dzięki tym informacjom lekarz ma możliwość doboru najbardziej efektywnej terapii, wybierając lekarstwo, które najlepiej sprawdzi się w walce z konkretnym szczepem bakterii.
Z własnego doświadczenia mogę powiedzieć, że umiejętność interpretacji wyników posiewu moczu oraz antybiogramu jest fundamentalna dla skutecznej i celowanej terapii. Taka wiedza pozwala na zminimalizowanie ryzyka powstania oporności bakterii na leki. Należy również mieć na uwadze, że różne szczepy mogą wykazywać zróżnicowaną wrażliwość na antybiotyki, dlatego indywidualne podejście do leczenia ma ogromne znaczenie.
Jakie są objawy zakażenia układu moczowego?
Objawy zakażenia układu moczowego (ZUM) przybierają różne formy i obejmują kilka kluczowych symptomów. Wśród najczęściej doświadczanych są:
- ból oraz pieczenie podczas oddawania moczu, znane jako dysuria,
- pilna potrzeba skorzystania z toalety, co może prowadzić do poliurii,
- wrażenie niepełnego opróżnienia pęcherza,
- zmiany w zapachu, kolorze i przejrzystości moczu.
Możliwe są również inne objawy, takie jak:
- mętny mocz lub mocz z domieszką krwi,
- ból w podbrzuszu,
- dolegliwości w rejonie lędźwiowym, które mogą wskazywać na poważniejsze infekcje, zagrażające nerkom.
Ból w dolnej części pleców nierzadko sygnalizuje bardziej zaawansowane zakażenie, które wymaga niezwłocznej interwencji.
Gdy zauważysz te objawy, kluczowe jest, aby zasięgnąć porady medycznej. Tylko lekarz może postawić trafną diagnozę. W wielu przypadkach konieczne są dalsze badania, takie jak posiew moczu, w celu potwierdzenia zakażenia. Symptomatologia zakażeń układu moczowego jest na tyle charakterystyczna, że sprzyja wczesnemu rozpoznaniu oraz skutecznemu leczeniu.
Jakie choroby i stany wymagają wykonania posiewu moczu?
Posiew moczu to niezwykle ważne badanie diagnostyczne, które wykonuje się, gdy pojawia się podejrzenie zakażenia układu moczowego. Wskazania do tego testu obejmują:
- ból podczas oddawania moczu,
- nagła potrzeba częstego wizytowania toalety,
- zmiany w barwie moczu,
- dolegliwości bólowe w podbrzuszu,
- ból w okolicy lędźwiowej.
Szczególną uwagę powinny na to zwrócić osoby z grup ryzyka, takie jak:
- kobiety w ciąży,
- seniorzy,
- pacjenci chorujący na cukrzycę.
Kiedy infekcje układu moczowego nawracają, rozsądnie jest pomyśleć o przeprowadzeniu kilku posiewów. Dzięki temu można lepiej zrozumieć źródło problemów oraz dopasować skuteczną terapię. Te badania mają istotne znaczenie w przypadku złożonych zakażeń, które wymagają bardziej zaawansowanej diagnostyki i efektywnego leczenia. Regularne monitorowanie stanu zdrowia w takich okolicznościach przynosi znacząco lepsze rezultaty.
Dodatkowo, zaleca się przeprowadzanie kontrolnych posiewów moczu w trakcie terapii oraz po jej zakończeniu. Umożliwia to ocenę efektywności leczenia oraz potwierdzenie pełnego wyleczenia. Posiew moczu jest więc kluczowym narzędziem zarówno w diagnostyce, jak i w leczeniu zakażeń układu moczowego, dostarczając dokładnych wyników, które są niezbędne do właściwego zarządzania zdrowiem pacjenta.
Jak wygląda terapia zakażeń układu moczowego na podstawie posiewu moczu?
Terapia infekcji układu moczowego opiera się głównie na wynikach posiewu moczu oraz analizie antybiogramu, co umożliwia dokładny dobór skutecznych antybiotyków. Gdy lekarze ustalą, jaki patogen wywołuje zakażenie, sprawdzają jego wrażliwość na dostępne leki. W przypadku lekooporności, może być konieczne zastosowanie alternatywnych środków, aby skutecznie poradzić sobie z infekcją.
Bardzo ważne jest również monitoring objawów w trakcie leczenia. Regularne kontrole oraz dodatkowe badania mogą okazać się niezbędne, aby dostosować terapię do zmieniającego się stanu pacjenta. Naszym celem jest nie tylko eliminacja objawów, ale również zapobieganie nawrotom zakażeń układu moczowego. Odpowiednie podejście terapeutyczne, oparte na dokładnej diagnostyce, znacznie zwiększa szanse na pełne wyleczenie i minimalizuje ryzyko powikłań.
Ważne jest, aby pamiętać, że każdy przypadek może wymagać indywidualnego podejścia. Skuteczność terapii najczęściej zależy od wczesnej interwencji oraz ścisłej współpracy z lekarzem.